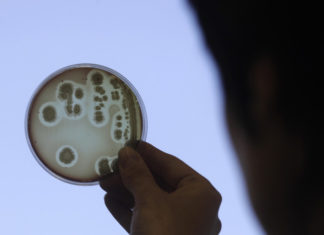
Ученые установили некоторые подробности «присасывания» бактерии к ДНК

Браузер Internet Explorer старой версии продолжает таить в себе опасность
Несмотря на то, что корпорация Microsoft продолжает улучшать и дополнять свой новый браузер Edge, он все равно остается...
Исследован скелет древнего кита, найденный в Перу
Сегодня специалисты из Королевского Бельгийского Института Естественных Наук представили новый исследовательский отчет,...
Ученые установили некоторые подробности «присасывания» бактерии к ДНК
Бактерии развиваются достаточно быстро – в частности, приобретая известную степень устойчивости против антибиотиков, на...
HMD добавила новый режим настроек камеры в Nokia 8
Современные модели Nokia 8 поколения так или иначе обладают разными интересными особенностями, за счет которых сами сма...
Walmart и Google запускают новый необычный проект
Совершать покупки – это нередко весело, интересно и… вызывает усталость. В особенности, если необходимо пройти определе...
Представлен способ обмануть детектор лжи
Детектор лжи представляет собой действительно интересный девайс, при помощи которого специалистам удавалось не раз раск...
Гравитационные волны в качестве передатчиков информации
Мы часто думаем о гравитации лишь в качестве некой силы, способной удерживать предметы на столе и нас самих от внезапно...
Руководство Blizzard опять обвиняется в сексуальных домогательствах
Буквально на этой неделе Департамент справедливого найма и жилья Калифорнии подал иск против крупного видеоигрового разр...
VLC Media Player обновляется до внедрения на macOS Big Sur
Одной из наиболее распространенных и востребованных к осуществлению видов деятельности на просторах сети является проиг...
AT&T вводит возможность оплачивать свои услуги биткоинами
Криптовалюта, несмотря на свою раннюю сомнительность, уже давно держится на прочных экономических основаниях – в частно...